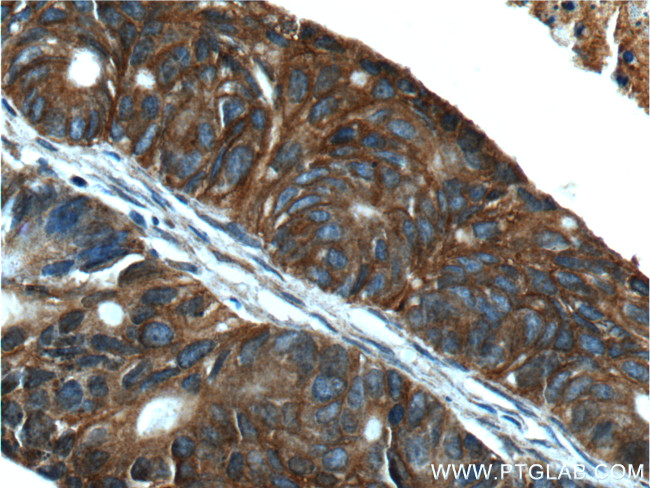
TMPRSS4 Antibody in Immunohistochemistry (Paraffin) (IHC (P))

Search
Proteintech
TMPRSS4 Polyclonal Antibody
{{$productOrderCtrl.translations['antibody.pdp.commerceCard.promotion.promotions']}}
{{$productOrderCtrl.translations['antibody.pdp.commerceCard.promotion.viewpromo']}}
{{$productOrderCtrl.translations['antibody.pdp.commerceCard.promotion.promocode']}}: {{promo.promoCode}} {{promo.promoTitle}} {{promo.promoDescription}}. {{$productOrderCtrl.translations['antibody.pdp.commerceCard.promotion.learnmore']}}
产品信息
11283-1-AP
种属反应
已发表种属
宿主/亚型
分类
类型
抗原
偶联物
形式
浓度
规格
纯化类型
保存液
内含物
保存条件
运输条件
产品详细信息
Immunogen sequence: PRKQLCDGE LDCPLGEDEE HCVKSFPEGP AVAVRLSKDR STLQVLDSAT GNWFSACFDN FTEALAETAC RQMGYSSKPT FRAVEIGPDQ DLDVVEITEN SQELRMRNSS GPCLSGSLVS LHCLACGKSL KTPRVVGGEE ASVDSWPWQV SIQYDKQHVC GGSILDPHWV LTAAHCFRKH TDVFNWKVRA GSDKLGSFPS LAVAKIIIIE FNPMYPKDND IALMKLQFPL TFSGTVRPIC LPFFDEELTP ATPLWIIGWG FTKQNGGKMS DILLQASVQV IDSTRCNADD AYQGEVTEKM MCAGIPEGGV DTCQGDSGGP LMYQSDQWHV VGIVSWGYGC GGPSTPGVYT KVSAYLNWIY NVWKAEL (72-437 aa encoded by BC011703)
靶标信息
This gene encodes a member of the serine protease family. Serine proteases are known to be involved in a variety of biological processes, whose malfunction often leads to human diseases and disorders. This gene was identified as a gene overexpressed in pancreatic carcinoma. The encoded protein is membrane bound with a N-terminal anchor sequence and a glycosylated extracellular region containing the serine protease domain. Multiple transcript variants encoding different isoforms have been found for this gene.
仅用于科研。不用于诊断过程。未经明确授权不得转售。
生物信息学
蛋白别名: CAPH2; Channel-activating protease 2; Channel-activating protease 4; channel-activating serine protease 2; mCAP2; Membrane-type serine protease 2; MT-SP2; Transmembrane protease serine 4; transmembrane protease, serine 4; transmembrane serine protease 3; type II membrane serine protease; unnamed protein product
基因别名: CAP2; CAPH2; mCAP2; MT-SP2; TMPRSS3; TMPRSS4; UNQ776/PRO1570
UniProt ID: (Human) Q9NRS4, (Mouse) Q8VCA5
Entrez Gene ID: (Human) 56649, (Rat) 367074, (Mouse) 214523